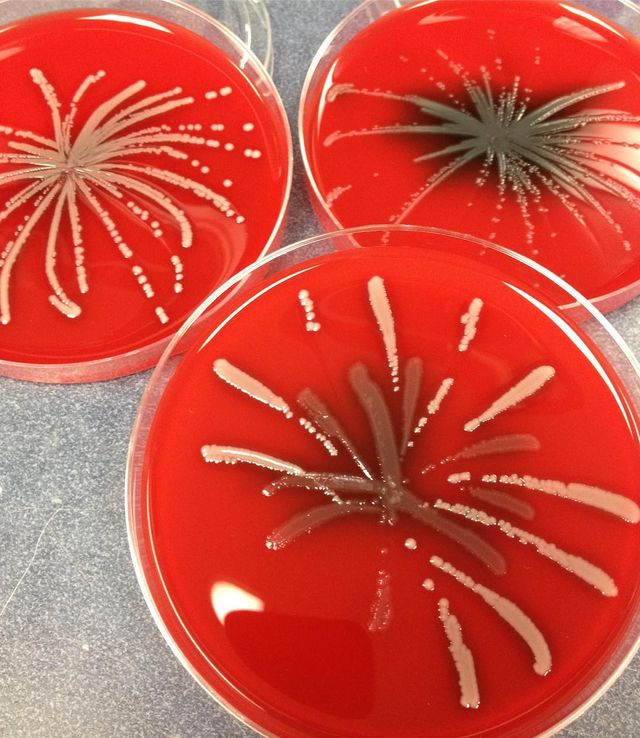
Мікробіолог створює малюнки за допомогою бактерій - фото 300538
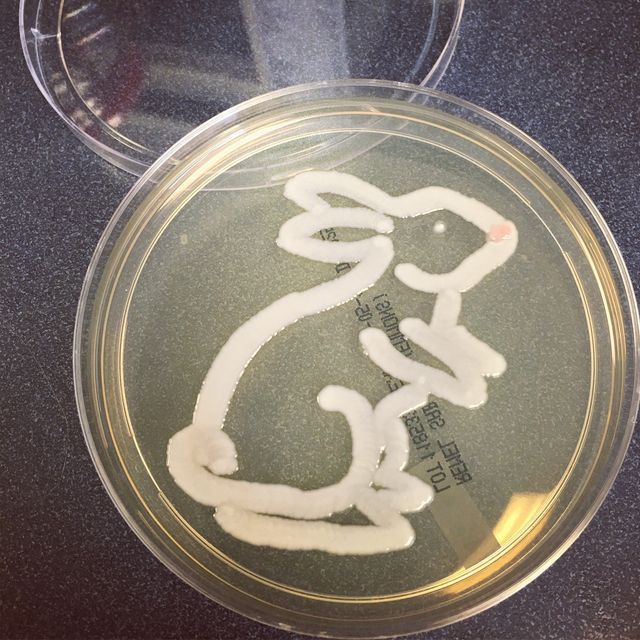
Мікробіолог створює малюнки за допомогою бактерій - фото 300539
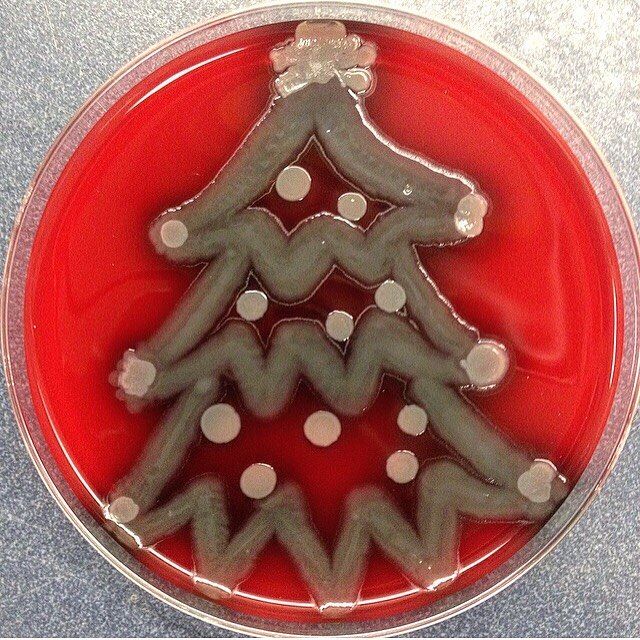
Мікробіолог створює малюнки за допомогою бактерій - фото 300541
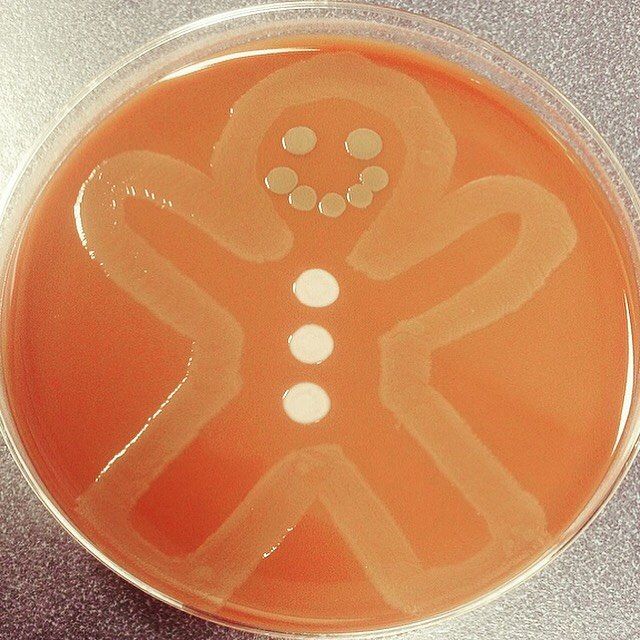
Мікробіолог створює малюнки за допомогою бактерій - фото 300542
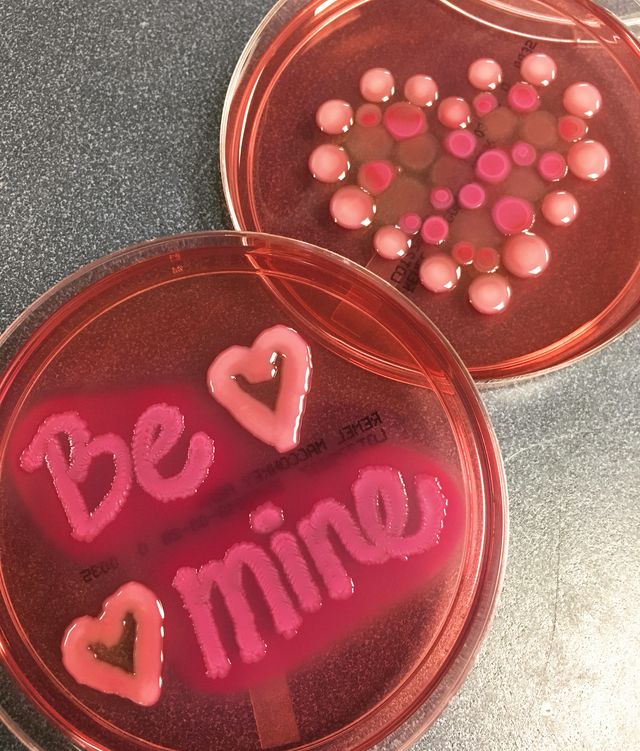
Мікробіолог створює малюнки за допомогою бактерій - фото 300543
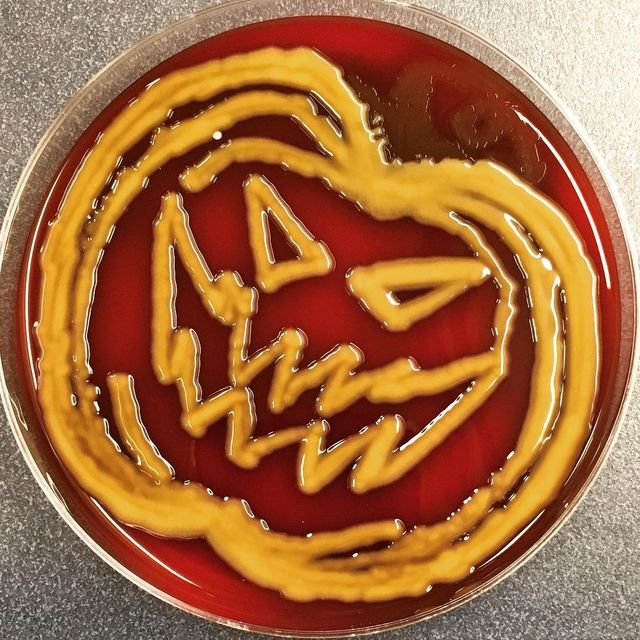
Мікробіолог створює малюнки за допомогою бактерій - фото 300544

На вказану електронну адресу було надіслано повідомлення для підтвердження реєстрації
Мікробіолог створює малюнки за допомогою бактерій
- 297
Акаунт американського мікробіолога в Instagram заповнений чашками Петрі, на дні яких виведені акуратні малюнки.
Коли Кейтлін вчилася у школі, в її лабораторії для підфарбовування кишкової палички використовували агар з еозином. Дівчина жартома сказала, що було б круто намалювати за допомогою бактерій ялинку. У результаті її однокласники влаштували конкурс на найкращий малюнок з бактерій.
І ще: Як виглядають картини, намальовані шоколадом
Зараз Кейтлін Каак – науковий співробітник лабораторії мікробіології в діагностичних лабораторіях Вісконсіна. Як стверджує Каак, її захоплення малюванням за допомогою бактерій допомагає пробудити у студентів інтерес до мікробіології.

Читайте також: Мінімалістичні знімки тайського фотографа, які заворожують
- 22 червня
-
23:10Як змінюються стосунки після двох років разом: що відбувається з почуттями насправді
-
22:00Чому ми закохуємося не в тих людей: психологи пояснили головний парадокс почуттів
-
21:22Яке свято відзначають 23 червня: традиції, заборони і прикмети на цей день
-
20:00Чому почуття гумору вважають однією з найважливіших складових щасливих стосунків
-
19:00Синдром головного героя: чому соцмережі змушують нас дивитися на життя як на кіно
-
 Українські патріотичні пісні: плейлист, який підіймає дух
Українські патріотичні пісні: плейлист, який підіймає дух
-
18:00Том Холланд підкорив Зендею танцем під Rihanna: інсайдер розкрив несподівану деталь
-
17:00Чому варто їсти шовковицю влітку: ягода, яка підтримує серце, зір і імунітет
-
16:00Цим трьом знакам зодіаку найчастіше пророкують славу та визнання: хто потрапив до списку
-
15:00Бегонія буде квітнути без зупинки: які умови потрібно створити для пишного цвітіння
-
14:00Морозиво зі свіжої полуниці без морожениці: як приготувати ніжний літній десерт удома
-
13:00Неприємний запах взуття зникне за ніч: два прості засоби, які є майже в кожному домі
-
12:00Ніколи не пишіть це на валізі: помилка, яка може коштувати багажу та особистих даних
-
11:00Топ-3 породи собак, які найчастіше вередують за столом: чому вони відмовляються від їжі
-
 З Днем народження: топ 75 привітань у картинках, віршах, прозі та смс українською
З Днем народження: топ 75 привітань у картинках, віршах, прозі та смс українською
-
10:00П’ять кольорів, які освіжать будь-який образ: що варто додати до гардероба вже зараз
-
09:00Не лише вода рятує у спеку: які напої допоможуть уникнути зневоднення влітку
-
05:30Зорі попереджають – 22 червня краще мовчати, ніж говорити зайве
- 21 червня
-
23:00Сергій Притула охрестив молодшого сина у Києво-Печерській лаврі: зворушливі кадри
-
22:05Катерина Кузнєцова назвала головний секрет щасливих стосунків
-
21:22Яке свято відзначають 22 червня: традиції, заборони і прикмети на цей день
-
21:00Чому ми постійно торкаємося обличчя: вчені знайшли несподіване пояснення
-
20:10Три знаки зодіаку, яким кінець червня принесе найбільше випробувань
-
19:40Скільки води потрібно пити щодня: проста звичка, яка допомагає серцю та судинам
-
18:10Чому досвідчені господині чистять раковину содою: простий спосіб повернути блиск
- 22 червня
-
21:22Яке свято відзначають 23 червня: традиції, заборони і прикмети на цей день
-
09:00Не лише вода рятує у спеку: які напої допоможуть уникнути зневоднення влітку
-
05:30Зорі попереджають – 22 червня краще мовчати, ніж говорити зайве
- 21 червня
-
21:22Яке свято відзначають 22 червня: традиції, заборони і прикмети на цей день
-
17:00День батька 2026: підбірка найкращих цитат про тата
-
15:00До Дня батька 21 червня: найкращі фільми про культових татусів
-
13:15Їм пощастить найбільше: ці 4 знаки Зодіаку стануть улюбленцями долі до кінця червня
-
12:00День батька в Україні: ТОП-20 коротких віршів про тата
-
11:10Злочинно красиво: Макс Барських презентує сиквел суперхіта "Не складається" – "Кольє"
-
10:47Том Голланд вперше відреагував на чутки про таємне весілля із Зендеєю
-
09:00Зворушливі та веселі пісні про тата до Дня батька 21 червня
-
05:30Літнє сонцестояння 2026: зірки назвали знаки, яким цей день відкриє новий етап
-
03:50Ти – наш супергерой: красиві й оригінальні привітання з Днем батька
- 20 червня
-
21:22Яке свято відзначають 21 червня: традиції, заборони і прикмети на цей день
-
13:00Як відрізнити натуральну шкіру від замінника: 3 прості способи перевірки перед покупкою
-
09:00Смузі для красивої засмаги: який напій допоможе зробити тон шкіри рівнішим влітку
-
05:30Зірки кажуть, що сьогодні стосунки важливіші за будь-які плани: прогноз на 20 червня
- 19 червня
-
21:23Яке свято відзначають 20 червня: традиції, заборони і прикмети на цей день
-
09:00Як зробити пишну зачіску без дорогих засобів: бабусині хитрощі, які знову стали популярним
-
05:30Зірки попереджають вас: 19 червня – день для завершення, а не для нових починань
- 18 червня
-
21:21Яке свято відзначають 19 червня: традиції, заборони і прикмети на цей день
-
10:10"Україна має талант" повертається: СТБ оголосив дату прем'єри та новий склад журі
-
05:30Гороскоп на 18 червня: зірки різко підвищують градус і вимагають від вас дії
- 17 червня
-
21:22Яке свято відзначають 18 червня: традиції, заборони і прикмети на цей день
-
13:00Чи потрібно стригти собак і котів у спеку: ветеринари пояснили, коли це шкодить







